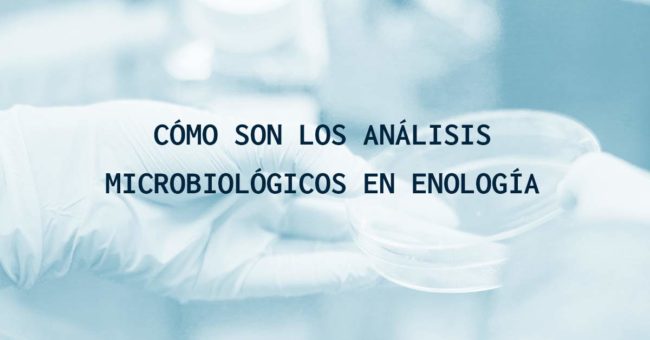

Calidad del agua de consumo humano, ¿qué tienes que saber?
¿Somos conscientes del privilegio que tenemos al hacer un simple gesto como abrir un grifo y que salga agua potable? En nuestra cultura quedaron atrás las largas caminatas con cántaros, a ríos o fuentes, para recoger el agua suficiente que supliera las necesidades básicas de la vida cotidiana. En muchos casos esta agua provenía de…